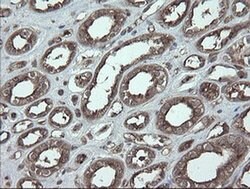
UBE2J1 Monoclonal Antibody (OTI3C11), TrueMAB , OriGene:Antibodies:Primary

Promotional price valid on web orders only. Your contract pricing may differ. Interested in signing up for a dedicated account number?
Learn More
Learn More
UBE2J1 Monoclonal Antibody (OTI3C11), TrueMAB™, OriGene


Mouse Monoclonal Antibody
$231.00 - $516.29
Specifications
| Antigen | UBE2J1 |
|---|---|
| Clone | OTI3C11 |
| Concentration | 1 mg/mL |
| Applications | Immunohistochemistry (Paraffin), Western Blot |
| Classification | Monoclonal |
| Catalog Number | Mfr. No. | Quantity | Price | Quantity & Availability | |||||
|---|---|---|---|---|---|---|---|---|---|
| Catalog Number | Mfr. No. | Quantity | Price | Quantity & Availability | |||||
50-253-9999
 

|
OriGene
TA504969S |
30 μL |
Each for $231.00
|
|
|||||
50-167-5544
 
|
OriGene
TA504969 |
100 μL |
Each for $516.29
|
|
|||||
Description
UBE2J1 Monoclonal antibody specifically detects UBE2J1 in Human samples. It is validated for Immunohistochemistry (Paraffin), Western BlotSpecifications
| UBE2J1 | |
| 1 mg/mL | |
| Monoclonal | |
| Liquid | |
| RUO | |
| IgG2a | |
| -20° C, Avoid Freeze/Thaw Cycles |
| OTI3C11 | |
| Immunohistochemistry (Paraffin), Western Blot | |
| Unconjugated | |
| Mouse | |
| Human | |
| Primary |
Spot an opportunity for improvement?Share a Content Correction
Product Content Correction
The Fisher Scientific Encompass Program offers items which are not part of our distribution portfolio. These products typically do not have pictures or detailed descriptions. However, we are committed to improving your shopping experience. Please use the form below to provide feedback related to the content on this product.
Product Title